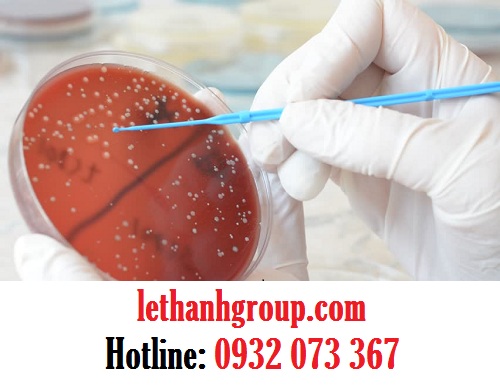

GĂNG TAY Y TẾ CHẤT LƯỢNG BÁN GIÁ SỈ GIAO HÀNG MIỄN PHÍ
Găng tay y tế chất lượng bán giá sỉ giao hàng miễn phí
CÁC SẢN PHẨM GĂNG TAY CÔNG TY LÊ THANH ĐANG SẢN XUẤT
♦♦♦
1* Găng tay len muối tiêu 40g, 50g, 60g, 70g, 80g
2* Găng tay len trắng kem 40g, 50g, 60g, 70g, 80g
3* Găng tay len xám đen 40g, 50g, 60g, 70g, 80g
4* Găng tay len poly trắng 40g, 50g, 60g, 70g, 80g
5* Găng tay vải thun cotton các loại
6* Găng tay len nhúng nhựa 40g, 50g, 60g,70g, 80g
7* Găng tay len hạt nhựa 40g, 50g, 60g, 70g, 80g
8* Găng tay vải jean
9* Găng tay vải mập
10* Găng tay vải mỏng các loại
11* Găng tay y tế các loại
12* Găng tay cao su gia dụng, công nghiệp, đa năng
13* Găng tay xốp, dẻo các loại
14* Găng tay phủ PU chống tĩnh điện các loại
Sự phát triển của thị trường găng tay y tế ở Việt Nam
Sở dĩ, vấn đề mua găng tay y tế chất lượng bán giá sỉ giao hàng miễn phí trở nên khó khăn hơn là sự phát triển không ngừng của thị trường găng tay y tế ở nước ta.
Trên thực tế, găng tay y tế chiếm khá nhiều trong các khoản chi phí của bệnh viện, cơ sở y tế, vì đây là loại bảo hộ lao động bắt buộc phải có khi khám, điều trị bệnh.
Bên cạnh đó, sự phát triển của công nghiệp chế biến thủy sản ở nước ta, đòi hỏi thêm một lượng găng tay lớn cho hoạt động sản xuất thủy hải sản,..Chỉ hai hoạt động này thôi thì đã yêu cầu một thị trường găng tay y tế đủ mạnh, đủ tiềm lực để cung cấp.
Mời quý khách click vào đây để xem thêm video & tin tức các sản phẩm khác của Công ty
Ngoài hai ngành trên, còn rất nhiều hoạt động từ trong cuộc sống hằng ngày đế trong sản xuất, làm việc đều cần găng tay y tế. Điều này khiến cho thị trường găng tay y tế nước ta ngày càng mở rộng và phát triển mạnh mẽ hơn bao giờ hết. Thế nhưng, việc phát triển này đi đôi với hệ lụy.
Người tiêu dùng khó mà tìm được nơi bán găng tay y tế chất lượng trong vô số những địa chỉ bán sản phẩm này trên thị trường. Họ đứng trước rất nhiều khó khăn khi mua găng tay y tế chất lượng, giá sỉ và cùng các dịch vụ khác đinh kèm như giao hàng miễn phí.
Mời quý khách click vào đây để xem thêm bài viết & tin tức các sản phẩm khác của Công ty
Vậy, cơ sở nào có thể cung cấp găng tay y tế chất lượng bán giá sỉ giao hàng miễn phí uy tín nổi trội trong rất nhiều địa chỉ bán găng tay y tế trên thị trường?
Địa chỉ bán găng tay y tế chất lượng bán giá sỉ giao hàng miễn phí uy tín
Nổi trội lên bằng sự uy tín, Lê Thanh cam kết bán găng tay y tế chất lượng bán giá sỉ giao hàng miễn phí cho khách hàng với những hỗ trợ hoàn hảo, tận tâm nhất.
Mời quý khách click vào đây để xem thêm hình ảnh & tin tức các sản phẩm khác của Công ty
Lê Thanh có nguồn găng tay y tế chất lượng, sử dụng dễ dàng, thuận tiện mà cực kì bền chắc. Độ co dãn, khả năng làm việc của găng tay y tế tại Lê Thanh được kiểm soát rất kĩ trước khi cung cấp sản phẩm cho khách hàng.
Chúng tôi đảm bảo rằng, găng tay y tế đến tay bạn là sản phẩm chất lượng nhất, được sàng lọc cụ thể, đảm bảo chất lượng công việc của bạn.
Đặc biệt, khi quý khách mua sỉ găng tay y tế tại Lê Thanh, ngoài dịch vụ giao hàng miễn phí , quý khách còn nhận được giá bán sỉ tốt nhất thị trường.
Giá sỉ này khiến cho khoảng phí phải chi cho găng tay của quý khách giảm thiểu ở mức tối đa. Không những thế, đối với khách hàng là đại lý, nhà phân phối lâu dài, Lê Thanh còn có nhiều ưu đãi, chương trình chiết khấu rất hấp dẫn, sẵn sàng cung cấp bất kì lúc nào.
Mua găng tay y tế chất lượng bán giá sỉ giao hàng miễn phí uy tín tại Lê Thanh nhanh chóng bằng cách liên hệ số 0932.073.367 và Mail: quangthanhboss@gmail.com. Bạn sẽ thấy không còn băn khoăn, lạc lối khi tìm mua găng tay y tế trong thị trường găng tay y tế rộng lớn ở nước ta nữa.

Xem thêm